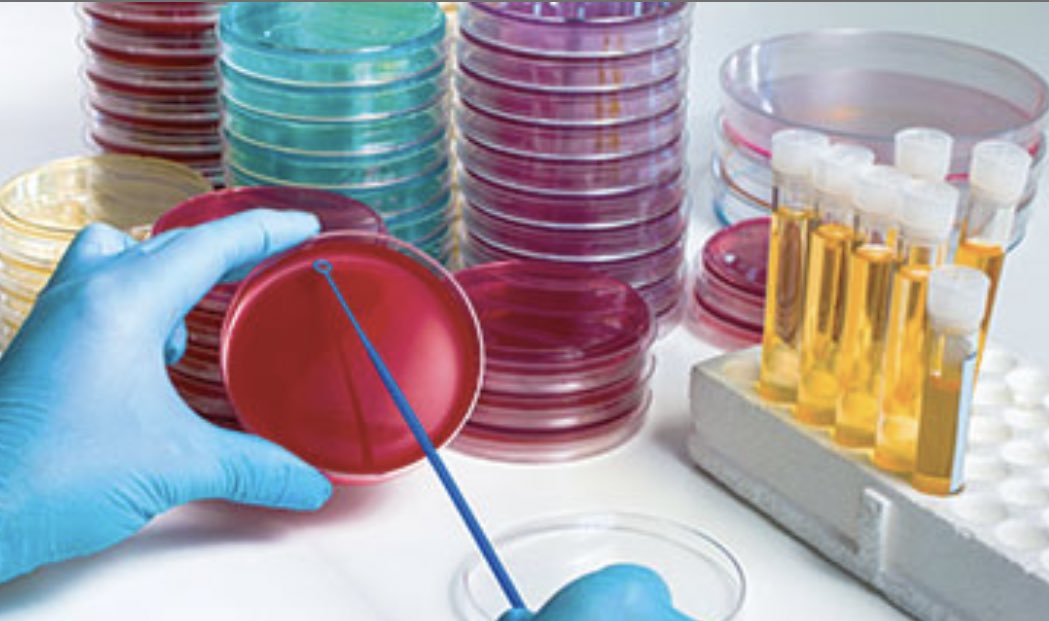
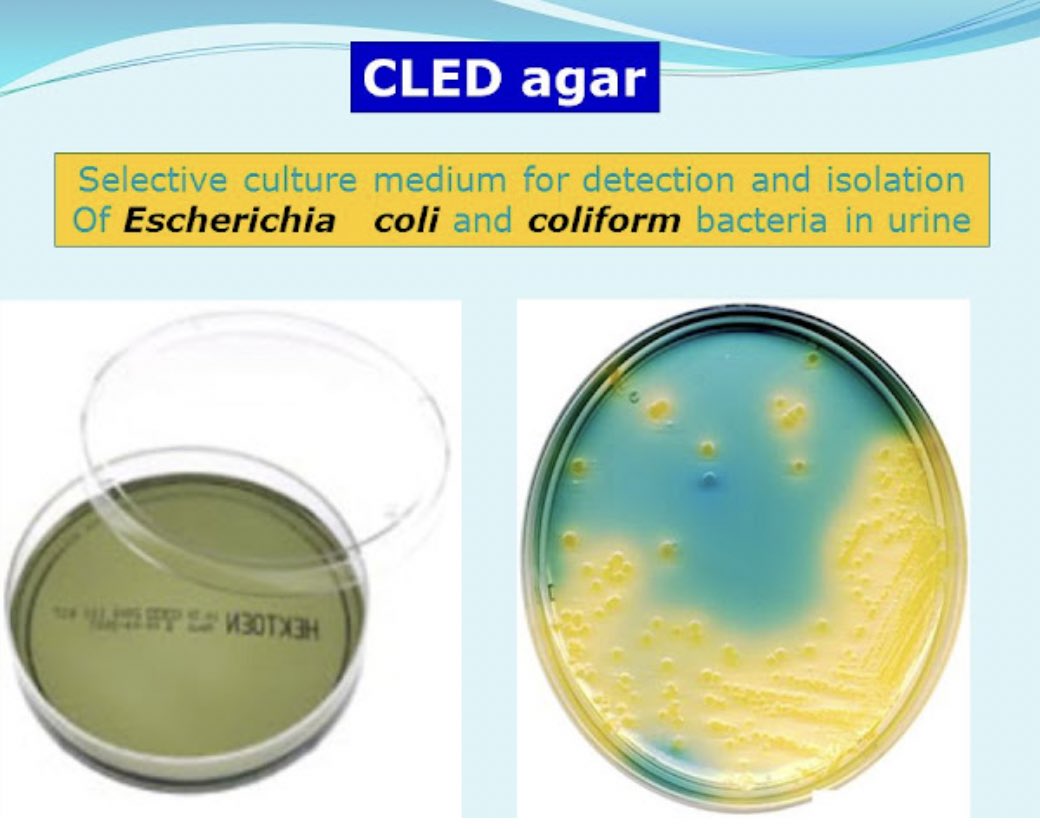
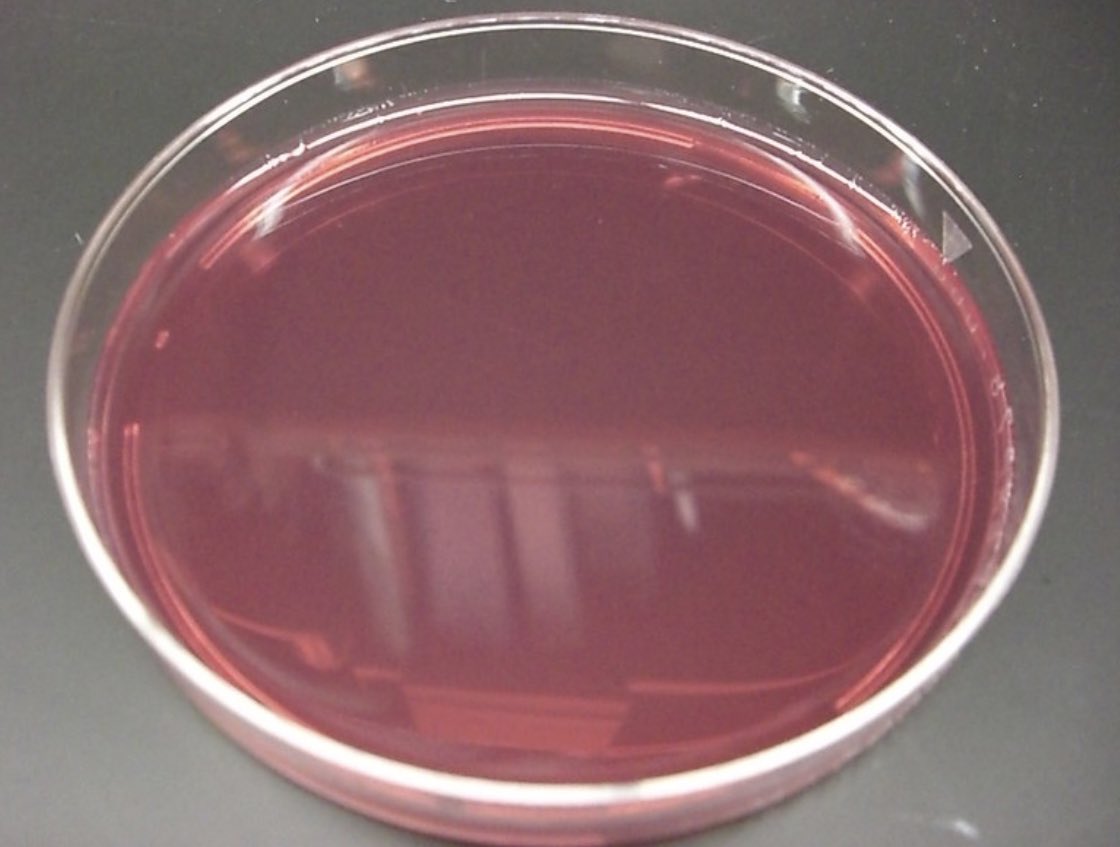
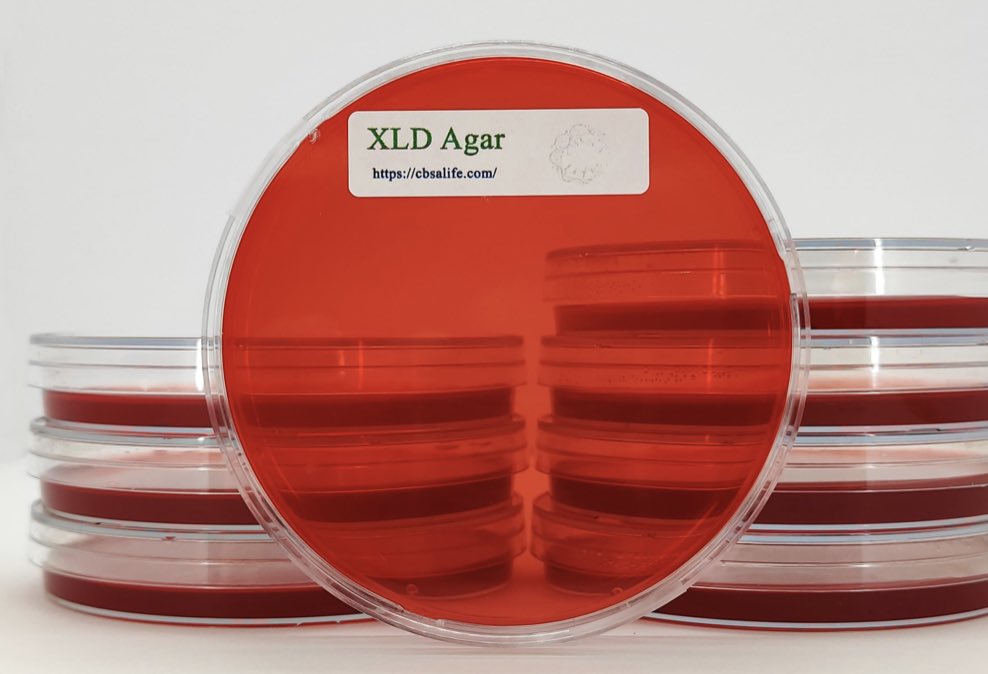
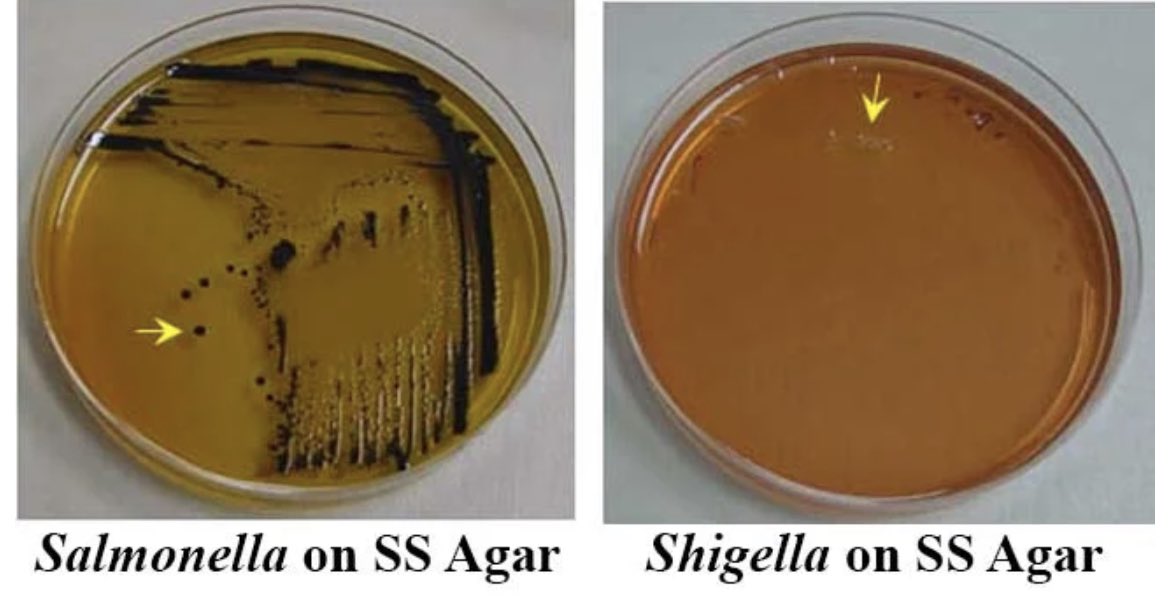
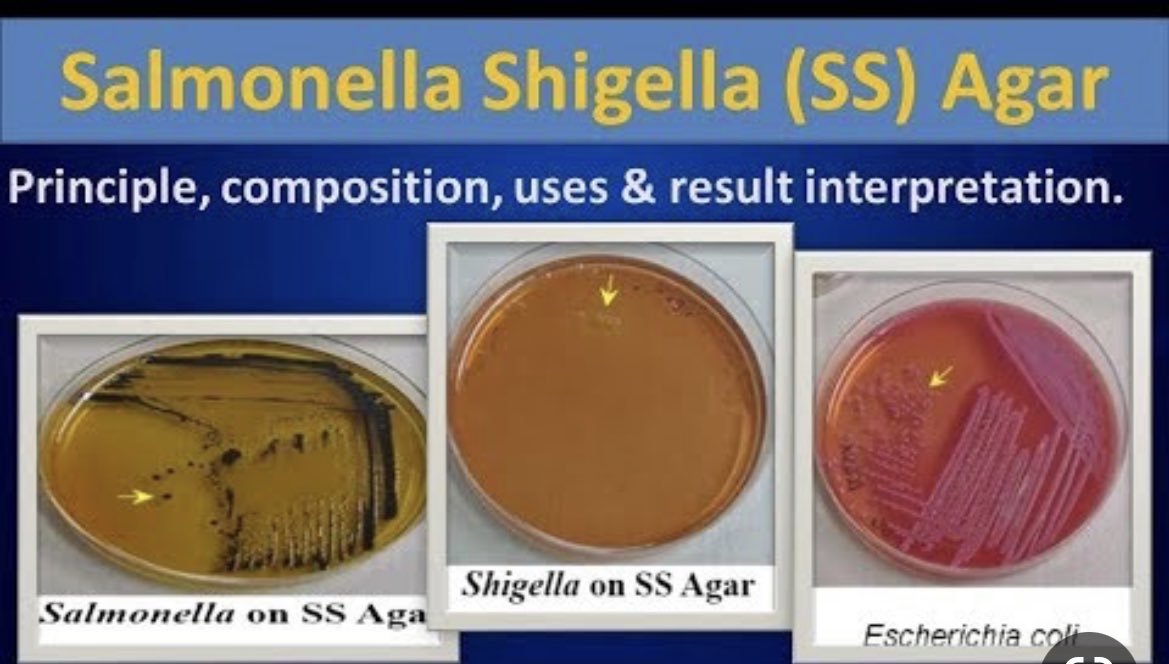
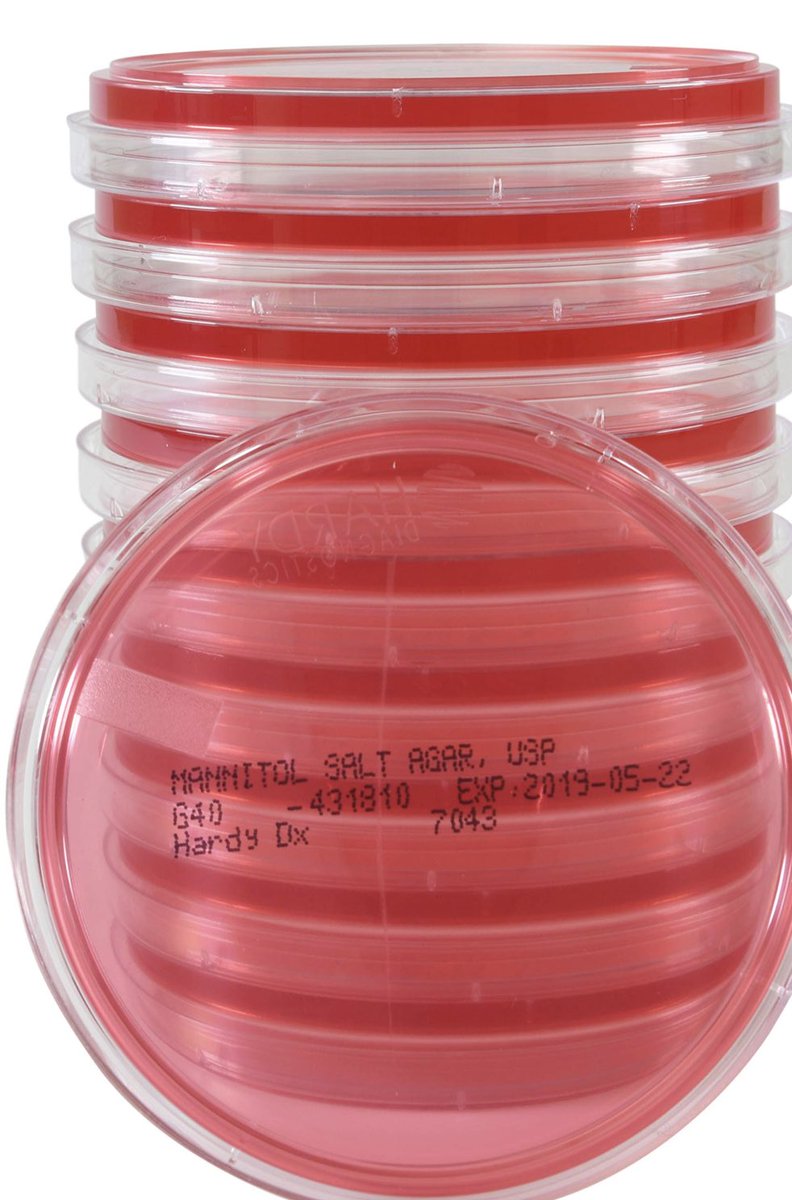
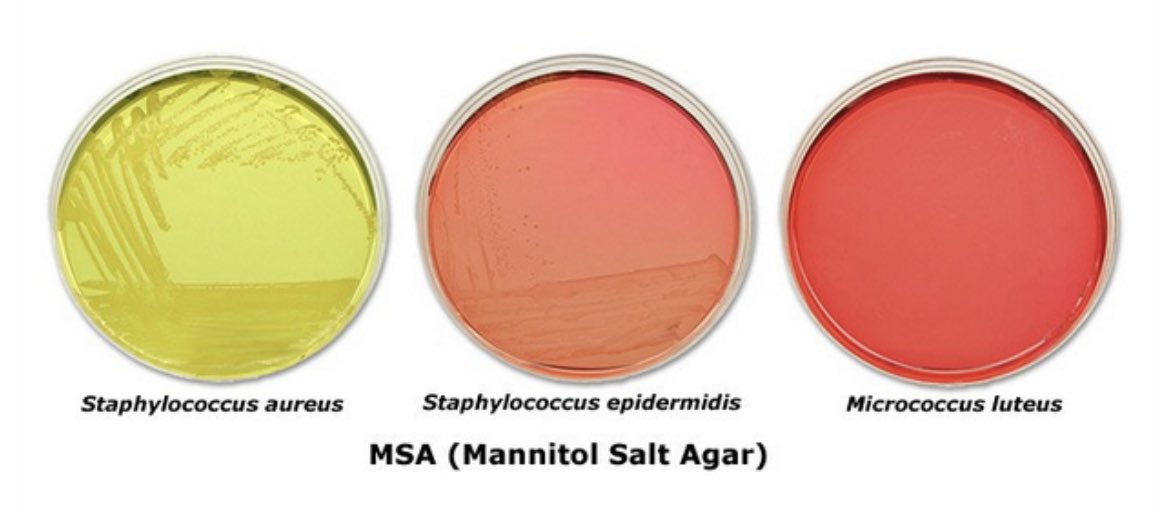
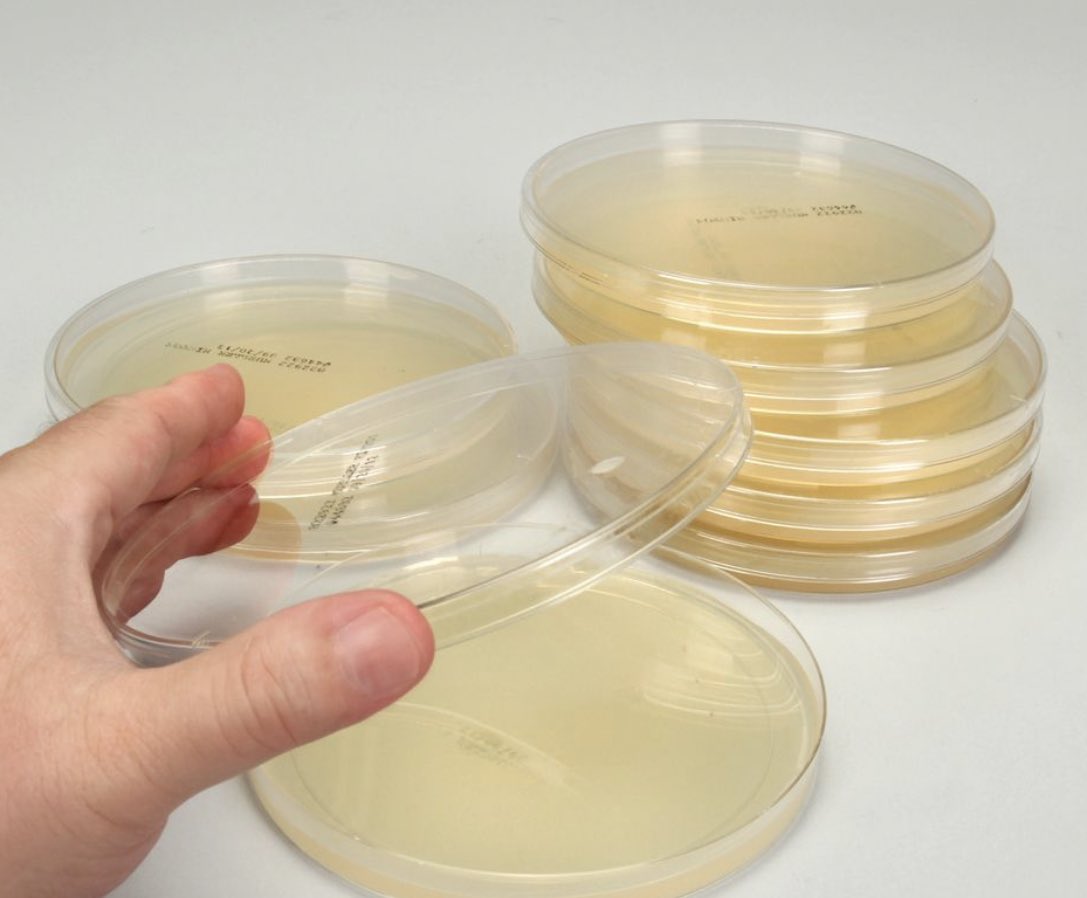
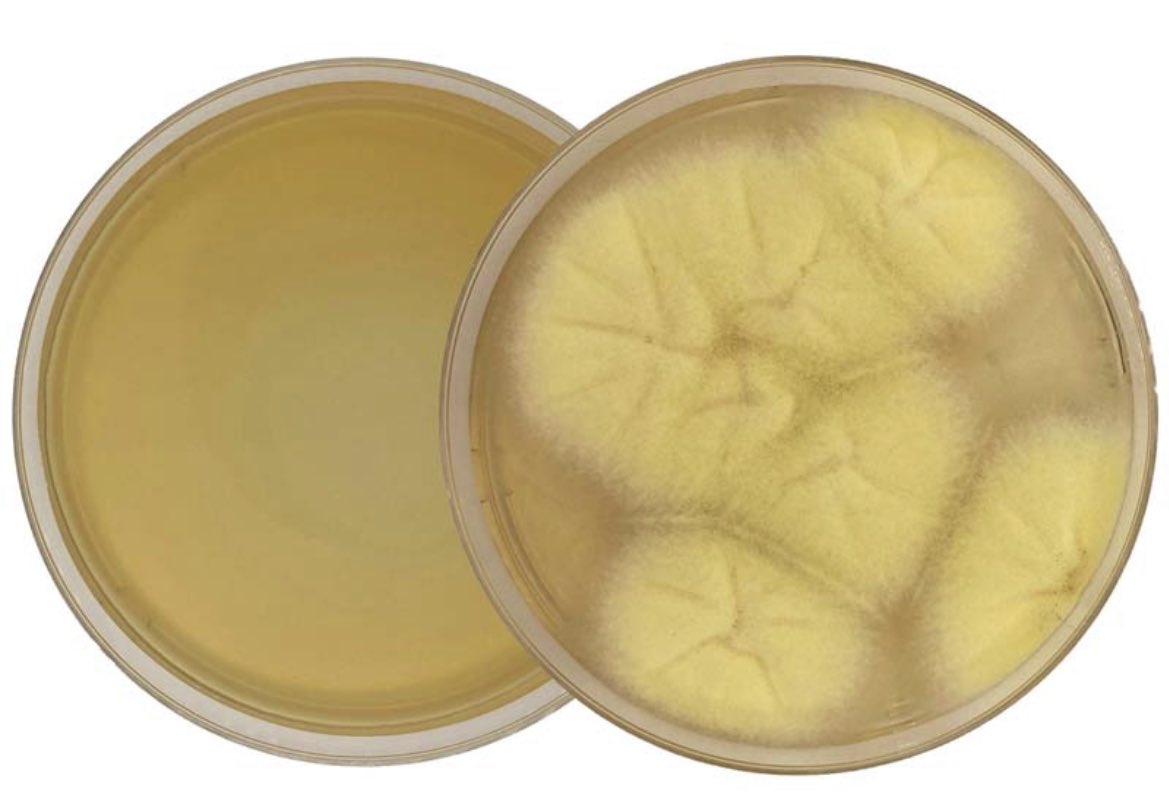

Sterpt Agalactiae أو التحلل الجزئي للدم مثل Alpha hemolytic
Sterpt Pneumonia
و Sterpt Viridans
أو عدم التحلل للدم Non hemolytic مثل
Sterpt Faecalis و Sterpt Bovis
Sterpt Pneumonia
و Sterpt Viridans
أو عدم التحلل للدم Non hemolytic مثل
Sterpt Faecalis و Sterpt Bovis
مثل Proteus و Salmonella و Shigella .
كما تحتوي على Crystal violet أو Bile Salts بحيث تسمح للبكتيريا السالبة لصبغة جرام بالنمو وتثبط نمو الموجبة لصبغة جرام
كما تحتوي على Crystal violet أو Bile Salts بحيث تسمح للبكتيريا السالبة لصبغة جرام بالنمو وتثبط نمو الموجبة لصبغة جرام
جاري تحميل الاقتراحات...